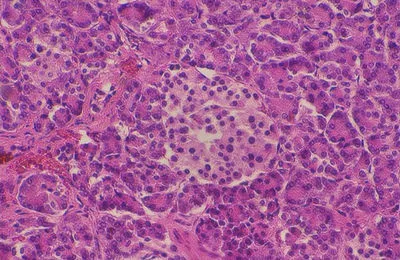
Prawidłowy obraz histologiczny trzustki. Przed cierpieniem związanym z piciem.

Zespół bolesnego barku
Zespół bolesnego barku to powszechnie występujące schorzenie układu mięśniowo-szkieletowego, dotykające zarówno osoby aktywne fizycznie, jak i prowadzone siedzący tryb życia. Objawia się bólem barku, nasilającym się zwłaszcza przy unoszeniu ręki ponad głowę, a w bardziej zaawansowanych przypadkach prowadzi do poważnych ograniczeń ruchomości. Choć na pierwszy rzut oka może wydawać się błahym problemem, nieleczony zespół bolesnego […]
Zespół bolesnego barku Dowiedz się więcej »